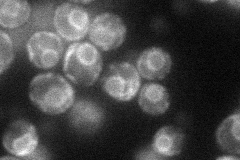
YNL095C
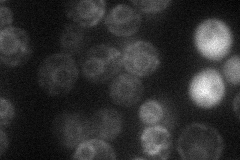
YNL095C
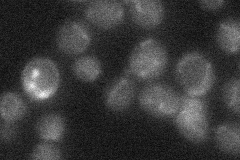
YNL095C
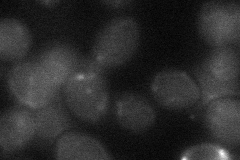
YNL095C

View description
Putative protein of unknown function predicted to contain a transmembrane domain; YNL095C is not an essential gene
Localization:
Intensity:
Fold change:
Significance:
-
C’ GFP library in SD

below threshold14.07 -
N' NOP1pr-GFP in SD
ER43.7066 -
N' TEF2pr-mCherry in SD
ER21.1219 -
N' NATIVEpr-GFP in SD
below threshold15.8911 -
N' TEF2pr-VC and Cyto-VN in SD
below threshold24.7325 -
C’ GFP library in SD+DTT

cytosol14.31.01No -
C’ GFP library in SD+H2O2

cytosol15.491.1No -
C’ GFP library in Starvation Media

cytosol17.341.23No -
C’ GFP library on the background of Pup2-DaMP

below threshold -
C’ GFP library on the background of CCT mutant

below threshold14.26441.01358No
